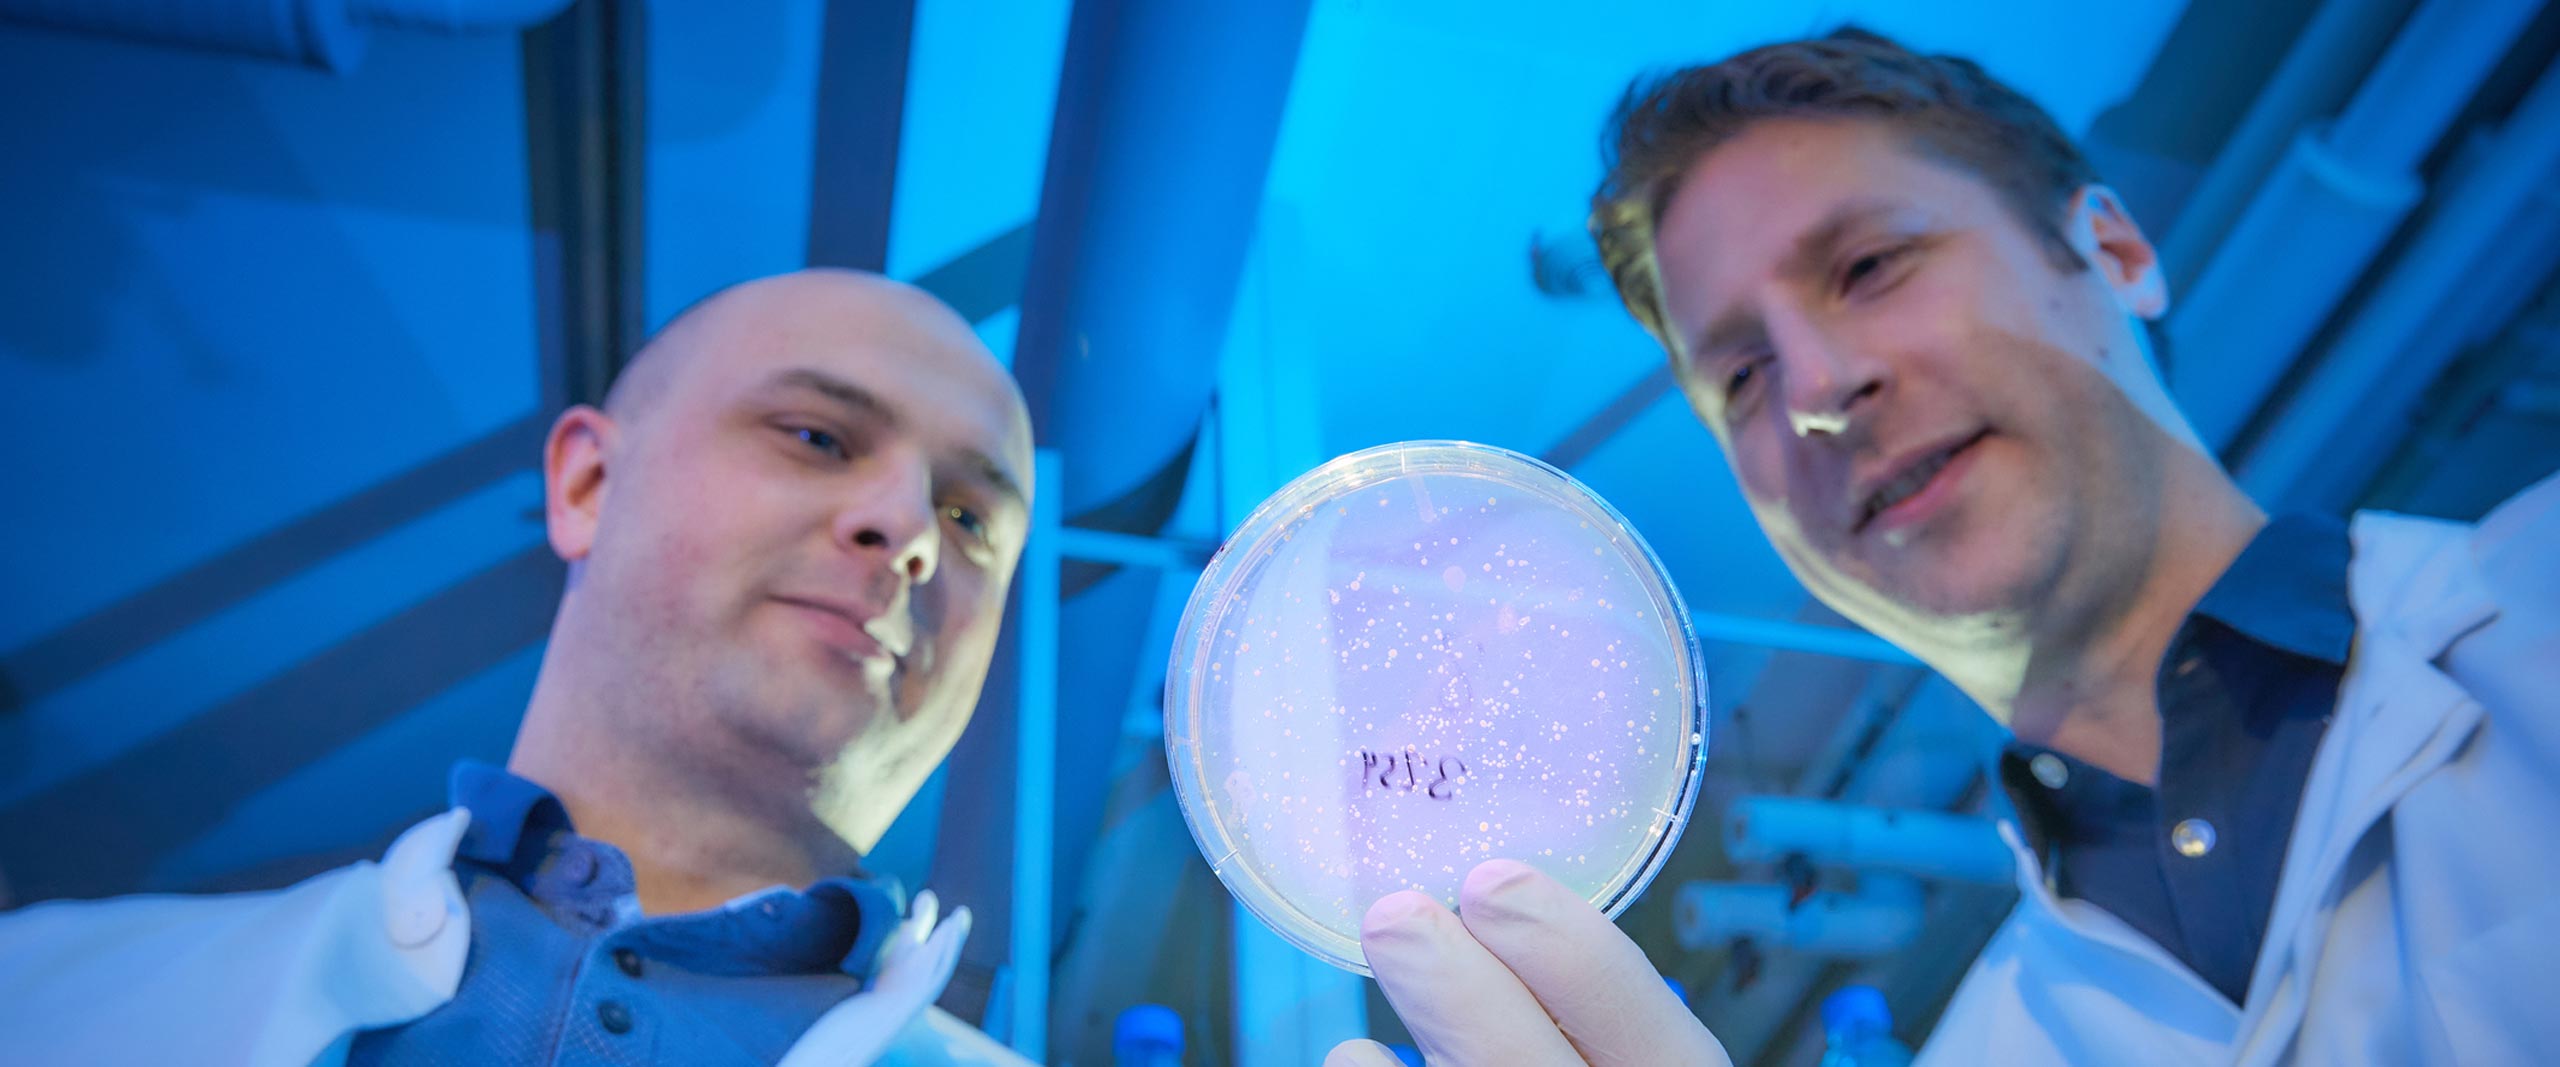

Neue Strategie für COVID-19-Prophylaxe
Forschende des Bonner Exzellenzclusters ImmunoSensation2 stimulieren gezielt den RNA-Rezeptor RIG-I
Bonn, 08. März 2022 – SARS-CoV-2-Viren können sich soweit tarnen, dass sie nicht vom Immunsystem erkannt werden. Der antivirale Immunrezeptor RIG-I lässt sich aber stimulieren, wodurch der Schutz vor tödlichen SARS-CoV-2-Infektionen verbessert wird. Das haben Forschende um Prof. Dr. Gunther Hartmann vom Institut… Weiterlesen